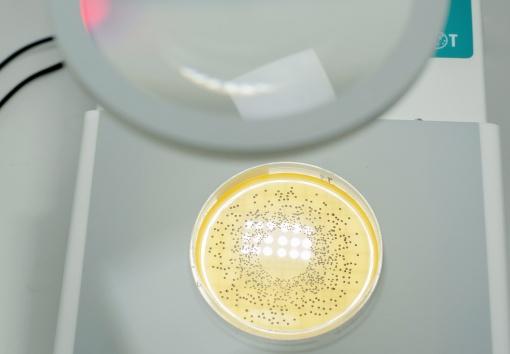

Counting colonies with the unaided eye is a slow, tedious, and sight-damaging task. IUL’s colony counter eases and quickens this process through the use of LED lighting and a high quality magnifying glass. Any microbiology lab involved in colony enumeration will find this tool to be absolutely vital. Petri plates are inserted inside the colony counter where they are properly lit and magnified. Operators can tick detected colonies with a specifically devised marker, meanwhile a digital display will increase the total counts. Pointers that can directly contact colonies are also available.
High Quality Magnification: IUL’s DOT Colony Counter has a large 120 mm diameter lens with a DINx2 magnification power.
Pointer Technology: Colonies are counted by directly touching these with a pointer or by marking them on the Petri dish with a felt tip pen.
Adapted for any plate: Multiple adapters are available 60 mm, 70 mm, 80 mm, 90 mm,100 mm, 120 mm, and 150 mm.
Send colony counts to PC applications through USB: Colony counts can be sent to PC applications such as a spreadsheet. Results are sent as standard PC keyboard keystrokes.
Lightning scalable intensities: Bottom light, 4 selectable intensities, On/Off switching powered from the instrument. Upper light (depending of the glass magnifier ordered), On/Off switching powered from the instrument.

We train our customers on the operation and installation .. We also offer after-sales service to follow our customers constantly and always check on our devices and the speed of providing maintenance service when necessary
Get Started For Free
© 2019 Grand Science. All rights reserved | Design by Hala Salah Eldin